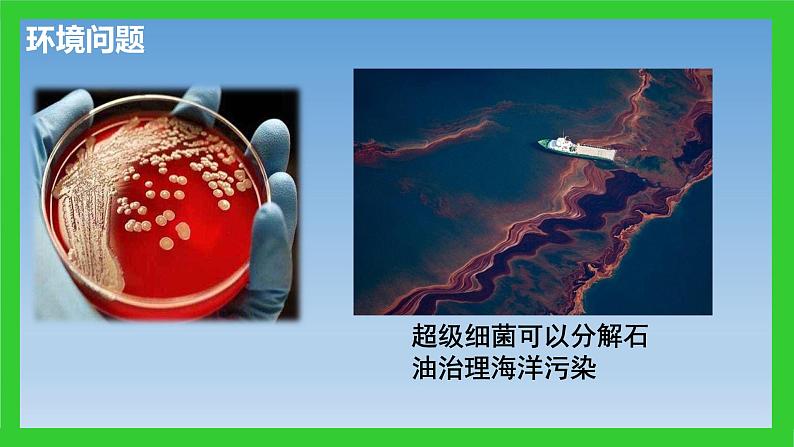

人教版 (2019)必修1《分子与细胞》第1节 细胞是生命活动的基本单位评课课件ppt
展开这是一份人教版 (2019)必修1《分子与细胞》第1节 细胞是生命活动的基本单位评课课件ppt,共27页。PPT课件主要包含了所有科目,社会发展的需求,缓解粮食危机,健康问题,环境问题,高中生物学什么,如何学习生物学,例如“细胞”,侧重于细胞的结构,侧重于现象等内容,欢迎下载使用。
一、为什么要学习生物?
1.个人发展的需求(高考的需求)
新高考政策:3+1+23 即语数外,各150分(全国统一命题)1 即物理、历史 二选一,各100分(省考试院命题)2 即思想政治、地理、化学、生物学 四选二 各100分(省考试院命题)
杂交水稻的研发是从1964年开始的,领衔人物就是袁隆平,由于袁隆平对杂交水稻的杰出贡献,后来人们也把袁隆平称为“杂交水稻之父”。1973年第一代杂交水稻研发成功,1976年开始在全国大面积推广,由于杂交水稻亩产比普通水稻高20%以上,所以,我国水稻产量随着杂交水稻的推广而节节攀升。
从1976年至2013年,全国累计种植杂交水稻近4亿公顷,累计增收稻谷约8000亿公斤
你是否知道这么一门学科——生物科学,在其中扮演了重要的角色吗?
当你在医院接种疫苗,预防疾病的时候
超级细菌可以分解石油治理海洋污染
主要是对生物的形态结构和生理特性进行简单描述
深入而抽象,重点探索生物基本原理和规律,联系实践应用
侧重于细胞的亚显微结构及功能
“光合作用”“呼吸作用”
认识神经细胞和免疫系统
重在理解,勤于思考;要重视科学研究的过程和方法,认真进行观察和实验;要重视理论联系实际,善于运用所学知识解释和解决生活中的实际问题;注重基础,重视表达。
预习,尝试完成知识梳理,找出问题。
做好笔记、积极思考、深入理解、精确记忆
认真并独立完成作业,及时纠错
明晰教材的知识体系,深入细化专项知识
①大熊猫和箭竹形态迥异,从结构上分析它们的共同之处是什么?
②如何证明它们在结构上有共同之处?
①没有显微镜之前,科学家是如何对生物进行观察和研究的?
②显微镜的发明对生物学领域带来哪些变化?
1.细胞学说的建立过程
列文虎克、马尔比基等都已观察到活细胞。
通过观察对花粉、胚珠和柱头组织的观察,理论概括出:植物体都是由细胞构成的;细胞是植物体的基本单位;新细胞从老细胞中产生。
通过观察大量动物细胞,提出:动物体也是由细胞构成的;一切动物的个体发育过程,都是从受精卵这个单细胞开始的。
施莱登和施旺共同提出了细胞学说
一切动植物体都是由细胞组成的;细胞是一切动植物体的基本单位。
归纳细胞学说的建立过程:
科学家是如何通过获得证据来说明动植物体由细胞构成这一结论的?
通过对动植体的解剖和显微观察获得证据,再通过归纳形成结论。
由具体事实推出结论的思维方法
2.细胞学说的主要内容
①细胞学说的主要内容有哪些?
③从细胞学说的建立与发展可以看出科学与技术有什么关系?
②细胞学说揭示了生物界的统一性还是多样性?
④细胞学说是否证明了一切生物都是由细胞构成的?
3.科学研究的方法之一:归纳法
施莱登和施旺只观察了部分植物和动物的组织,却归纳出“所的动植物都是由细胞构成的“,这一结论是否可信?
从细胞学说的建立过程,你领悟到科学发现具有哪些特点?
①科学发现需要从观察入手;②科学发现的过程离不开技术的支持;③科学理论的形成需要观察与归纳概括相结合;④科学学说的建立是一个不断修正和发展的过和程
科学假说(理论)的提出通常建立在不完全归纳的基础上,因此常常需要进一步的检验。
指由一系列具体事实推出一般结论的方法。
四、生物体的生命活动离不开细胞
1、无细胞结构的病毒是如何完成其生命活动的?
2、单细胞生物体如变形虫如何完成生命活动?
3、多细胞生物体的生命活动如何完成?
4.一个分子或一个原子,也是一个系统吗?他们是不是生命系统?如果不是,请说明原因。
结论:____________是最基本的生物生命系统,生命活动的进行离不开细胞。
五、生命系统的结构层次
四、生命系统的结构层次
A.一切动物和植物都由细胞发育而来,并由细胞及其产 物构成
1.德国科学家施莱登和施旺建立的“细胞学说”,是生物学科学史上的一座丰碑。下列关于“细胞学说” 的说法,不正确的是( )
D.细胞学说阐明了生物界的统一性和多样性
C.细胞是一个相对独立的有机体,又对与其他细胞共同 构成的整体的生命起作用
B.魏尔肖总结出“细胞通过分裂产生新细胞” 是对细 胞学说的修正和补充
2. T2噬菌体没有细胞结构,是一种专门寄生在大肠杆菌内的病毒,在适宜的条件下, T2噬菌体可以利用大肠杆菌体内的物质、能量等进行遗传、繁殖等生命活动。 绿眼虫和变形虫虽然是都单细胞生物,但是它们可以象多细胞的雨蛙一样完成运动、摄食、消化、繁殖等生命活动。
(1)以上事例说明_____________________________________。
(2)从生命系统的结构层次来看,一条小河中所有的雨蛙构成________,雨蛙和变形虫等所有的生物构成______。
相关课件
这是一份高中生物人教版 (2019)必修1《分子与细胞》第1节 细胞是生命活动的基本单位示范课ppt课件,共31页。PPT课件主要包含了情景导入,学习目标,问题探讨,用时5分钟,施莱登和施旺,时间5分钟,在教材中用笔勾画出来,细胞是基本的生命系统,知识补充,生命系统的结构层次等内容,欢迎下载使用。
这是一份人教版 (2019)必修1《分子与细胞》第1章 走近细胞第1节 细胞是生命活动的基本单位教课内容ppt课件,文件包含第1章第1节细胞是生命活动的基本单位pptx、第1章第1节细胞是生命活动的基本单位doc等2份课件配套教学资源,其中PPT共29页, 欢迎下载使用。
这是一份人教版 (2019)必修1《分子与细胞》第1节 细胞是生命活动的基本单位示范课课件ppt,共33页。PPT课件主要包含了一细胞学说,理论归纳阶段,修正中前进等内容,欢迎下载使用。